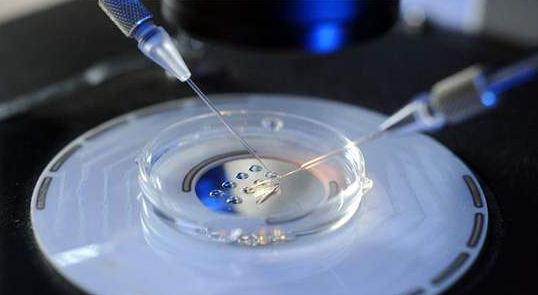
成都正规试管代怀价格帮助不孕不育家庭找到获得孩子的方法

一、成都卖卵
成都卖卵,这是一个让人十分震惊的消息。卖卵是指将女性卵子进行交易的行为,这种行为在很多国家都是非法的,但在四川省成都市的一些地下市场中却是普遍存在的。
据报道,成都市的一些女性为了赚取足够的钱,选择卖卵。她们会被要求提供身份证、护照和其他证件,然后被带到一些地下市场进行交易。在一些情况下,女性甚至需要被强制进行手术,将卵子取出。
这种行为是非法的,它不仅侵犯了女性的身体和尊严,也给整个家庭和社会带来了巨大的伤害。女性们卖卵的原因也各不相同,但她们普遍感到无助和绝望。
作为一个文明社会,我们应该尊重女性的权利和尊严,保护她们的身体和心理健康。我们也应该加强对这种非法行为的打击力度,保护整个社会的利益。如果有任何疑问或建议,欢迎向相关部门或组织提出。二、成都怎么取卵子
成都取卵子是一种对女性生育能力的检查方法。在这种方法中,医生会通过对女性的生殖器官进行检查,并利用技术手段取出一定数量的卵子。这些卵子是女性生育后代的重要资源,因此,成都取卵子的过程也备受关注。
成都取卵子的过程通常包括以下几个步骤:
1. 检查女性的身体健康状况,确保她们适合进行取卵子手术。
2. 通过生殖器官进行检查,确定卵子的位置和数量。
3. 使用特殊的设备,将女性的卵子从卵巢中取出。
4. 对卵子进行处理,确保它们可以安全地存储和使用。
5. 将卵子实验室进行进一步处理,以确定它们的健康状况和是否适合用于受精。
通过成都取卵子的过程,医生可以确定女性的生育能力,并计划未来的生育计划。同时, 成都取卵子的过程也可以帮助女性更好地了解自己的生殖健康,从而更好地保护自己的生育能力。三、成都市妇幼保健院推荐理由
到成都市妇幼保健院就医的人群并不少,为了便于更多人了解成都市妇幼好不好,柚喜网特地收集了部分在该院就诊夫妻的真实评价,供姐妹们参考。
贵州网友
王雪梅老师是一位性格好,工作严谨!专业到位!希望跟我一样在备孕中经厉很多磨难的姐妹们都能有幸认识王老师,在王老师的治疗下能顺利的怀上宝宝!
西安网友
王医生是一个和蔼可亲的医生很有耐心,感谢王王医生让我愿梦做上了一个妈妈我很激动,手术后一直挂不到你的号后来找了林医生给我安排移植和保胎,遇上了林医生也就是我的福星,总之千言万语内心感激,祝你和林医生身体健康生活如意!
四川网友
我是去做试管婴儿,目前还在进行中,余医生态度很好,交代事情也清楚,是个好医生,总之这个医院目前来说感觉还是很不错的,也希望自己在这个医院能如愿怀上健康宝宝。

![<strong>天津第三代试管婴儿医院费用[天津试管婴儿]</strong>](https://img.wytfox.com/y244s22/wytfox_com/2025/11/20/19/77f24a4eb71103b0e17c353f8f382061.jpg)














![福建正规职业代怀,去做试管婴儿要花多少钱[详细说明]](https://img.wytfox.com/y244s22/wytfox_com/2025/11/20/18/98a58aaadd8f920c132936dd2b477303.jpeg)

